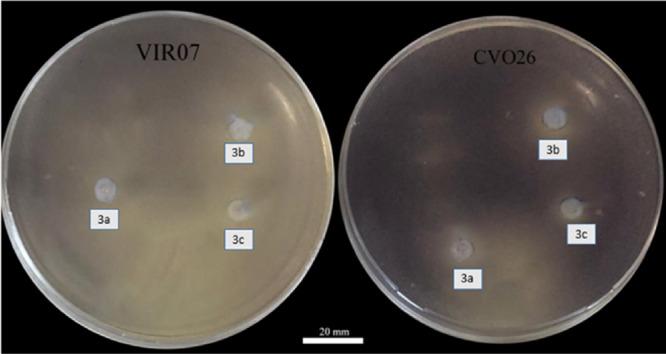
https://cdn.ncbi.nlm.nih.gov/pmc/blobs/b812/11974491/7b49aa22c39c/JBT-39-e70248-g006.jpg

新型1,3-二取代2-巯基-1H-苯并[d]咪唑氯化物的合成、细胞毒性活性、群体感应抑制作用、对接及分子动力学模拟
Synthesis, Cytotoxic Activity, Antiquorum Sensing Effect, Docking and Md Simulation of Novel 1,3-Disubstituted 2-Mercapto-1H-Benzo[D]Imidazolium Chlorides.
作者信息
Mavvaji Mohammad, Muhammed Muhammed Tilahun, Onem Ebru, Aslan Halime Güzin, Alhag Sadeq K, Akkoc Senem
机构信息
Faculty of Pharmacy, Department of Basic Pharmaceutical Sciences, Suleyman Demirel University, Isparta, Türkiye.
Faculty of Pharmacy, Department of Pharmaceutical Chemistry, Suleyman Demirel University, Isparta, Türkiye.
出版信息
J Biochem Mol Toxicol. 2025 Apr;39(4):e70248. doi: 10.1002/jbt.70248.
A series of benzimidazolium chlorides (2a-c) and their corresponding 2-mercapto derivatives (3a-c) were proficiently synthesized and analyzed by NMR and LC-MS spectra. The in vitro cytotoxic assay demonstrated that some synthesized compounds were active on the cancer cell lines. The binding potential of the most active three compounds to topoisomerase II alpha (topo2α) was explored to unveil the possible mode of action for the cytotoxic activity. The binding potential was examined through molecular docking. The stability of compound-enzyme complexes from docking was investigated through molecular dynamics (MD) simulation. The docking study revealed that the three compounds (3a-c) showed the ability to bind to the enzyme. However, the binding strength of compounds was weaker than that of the standard drug, doxorubicin. The MD simulation analysis demonstrated that compounds 3a and 3b gave relatively stable complexes with the enzyme and thus they would remain inside the binding pocket during the simulation period. Furthermore, the pharmacokinetic properties of the relatively active compounds were computed in silico. The computation disclosed that all of compounds exhibited drug-like properties. It is worth mentioning that all of them were found to be nontoxic. In furtherance, the inhibitory effect of compounds (3a-c) on the quorum sensing system was inspected using the biomonitor strains Chromobacterium violaceum 026, Chromobacterium. violaceum VIR07 and Pseudomonas aeruginosa PAO1. In this regard, we focused on the appraisal of the virulence factors, including pyocyanin, elastase, and biofilm formation that are created by P. aeruginosa PAO1 as the source of infectious diseases. As a result, it was determined that all examined compounds displayed statistically significant inhibition effects, and the highest activity was observed on elastase production with an inhibition rate of 84-86%.
一系列苯并咪唑鎓氯化物(2a - c)及其相应的2 - 巯基衍生物(3a - c)被成功合成,并通过核磁共振(NMR)和液相色谱 - 质谱(LC - MS)光谱进行分析。体外细胞毒性试验表明,一些合成化合物对癌细胞系具有活性。研究了三种活性最高的化合物与拓扑异构酶IIα(topo2α)的结合潜力,以揭示其细胞毒性活性可能的作用方式。通过分子对接研究结合潜力。通过分子动力学(MD)模拟研究对接得到的化合物 - 酶复合物的稳定性。对接研究表明,这三种化合物(3a - c)具有与该酶结合的能力。然而,化合物的结合强度比标准药物阿霉素弱。MD模拟分析表明,化合物3a和3b与该酶形成相对稳定的复合物,因此在模拟期间它们将保留在结合口袋内。此外,在计算机上计算了相对活性化合物的药代动力学性质。计算结果表明,所有化合物均表现出类药物性质。值得一提的是,发现它们均无毒。此外,使用生物监测菌株紫色杆菌026、紫色杆菌VIR07和铜绿假单胞菌PAO1检测了化合物(3a - c)对群体感应系统的抑制作用。在这方面,我们重点评估了由作为传染病源的铜绿假单胞菌PAO1产生的毒力因子,包括绿脓菌素、弹性蛋白酶和生物膜形成。结果确定,所有检测的化合物均表现出统计学上显著的抑制作用,并且在弹性蛋白酶产生方面观察到最高活性,抑制率为84 - 86%。